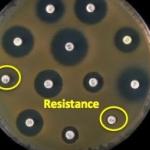

This is Antibiotic Awareness Week.
CRE
This is not the MRSA pandemic, ladies and gentlemen. Let's take a look at the MRSA pandemic. In US hospitals, even today (latest CDC data is from 2014), 46% of S.
I have been writing for years (1) about the emergence and spread of bacteria that are resistant to virtually all antibiotics, and that it was only a matter of time until they reached the US. Time's up.